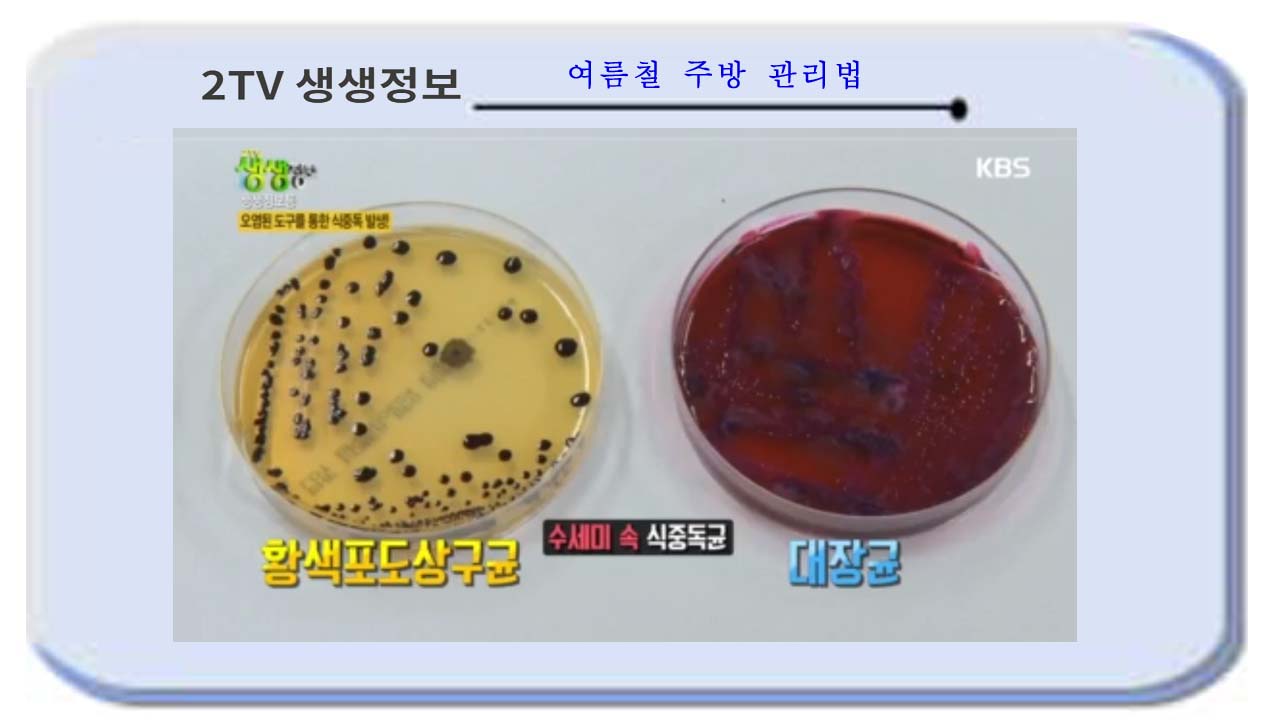

여름철 똑똑한 주방관리법 [2tv생생정보]
여름철 똑똑한 주방관리법을
2tv생생정보에서 소개했습니다

고온다습한 여름철 특히 장마철에는
식중독에 주의를 해야 하는데 고온다습을
즐기는 살모넬라균 여름철에는 식중독이
많이 증가한다는데 장마철 습한 날씨에는
식중독균이 기승을 부리기 때문에
음식물을 실온에 방치하는 것은 금물입니다

주방 곳곳에 숨어 있는 세균
고온 다습한 상황에서는 세균이 번식을
잘 할 수가 있다 합니다
주방에서 사용하는 헹주의 세균을
측정해 보니 정부에서 권고하는 공중위생
기준치는 400rul인데 도마와 수세미에서
측정한 세균의 측정값은
도마에서는 3,000 그리고 수세미에서는
5,000이 넘어 갑니다

행주속에서 나온 식중독 균은
살모넬라균과 대장균

수세미속의 식중독균은
황색포도상구균과 대장균
도마속에는 황색포도상구균이 검출이
되었습니다

식중독에 걸렸을 때 주된 증상은 설사이며
구토를 유발하기도 한답니다
나이가 많거나 아이들 같은 경우에는
탈수되면서 콩팥 기능에 손상이 오거나
심각한 합병증이 올수도 있다 합니다

주방도구를 깨끗하게 소독하는 방법
필요한 재료는 생강과 베이킹소다, 소금,
소주, 분무기

먼저 소금과 베이킹소다를 1 : 1 비율로
섞어 줍니다
도마 표면에 뿌린 후 약 3분간 문지릅니다
그리고 도마를 물로 헹굽니다

생강껍질에 소주를 붓고 숙성을 시킵니다

한 달에 2번 소독 후 1년 주기로 도마를
교체해 줍니다

생강을 먹었을 때 특유의 향과 매운맛이
나는데 바로 진저롤 성분 때문입니다
이러한 화학 성분은 살균 능력이 매우
뛰어나기 때문에 도마에 있는 식중독균에 닿을
경우 균을 죽일 수가 있어서 결과적으로
소독 효과를 볼 수가 있다 합니다

행주와 수세미 소독하기
물 2컵과 주방세제 소주잔 1/3컵을 넣고
섞어 줍니다
전자레인지에 4분간 돌린후 물로 행굽니다
한 달에 1번 행주와 소세미를 교체하는
것이 좋다 합니다


바이러스와 세균들은 냉장고에 있다고
균이 죽지는 않는다 합니다
증식되는 속도만 떨어질 뿐이고
해동을 하면 다시 증식을 시작한답니다

냉장고도 오염도를 측정해 보자 오염이 된
것을 확인할 수가 있습니다

냉장고 청소용액 만들기
먼저 레몬즙을 짭니다
레몬즙과 물을 1 : 10 비율로 섞은 후
베이킹소다 1스푼을 넣어 줍니다

골고루 뿌린 후 청소를 해 줍니다
냉장고를 청소할 때에는 가급적으로
빠른 시간 내에 하는 것이 좋습니다

수박을 보관할 경우에도 한 입 크기로 잘라서
밀폐용기에 넣어서 보관을 합니다
다른 고기들보다 빨리 상한다는 닭고기
3~4일 이내에 금방 먹을 닭 보관법과
오랫동안 두었다가 먹는 보관법이 다르답니다
닭 단기 보관법은
닭 표면에 식용유를 바른 후 랩에 싸서
냉장 보관을 합니다

닭 장기 보관법
닭을 밀폐용기에 넣고 소금과 청주로
밑간을 한 후 냉동 보관합니다

잎채소 보관법
채소를 씻은 후 밀폐용기에 종이행주와
잎채소를 겹겹이 얹습니다
뚜껑을 덮어 뿌리 쪽이 아래로 향하도록
세워서 보관합니다

식중독 예방을 위한 다양한 방법들에
대하여 알아 보았습니다
어렵지 않은 방법이라서 누구나 쉽게
할 수가 있습니다
항상 건강하세요